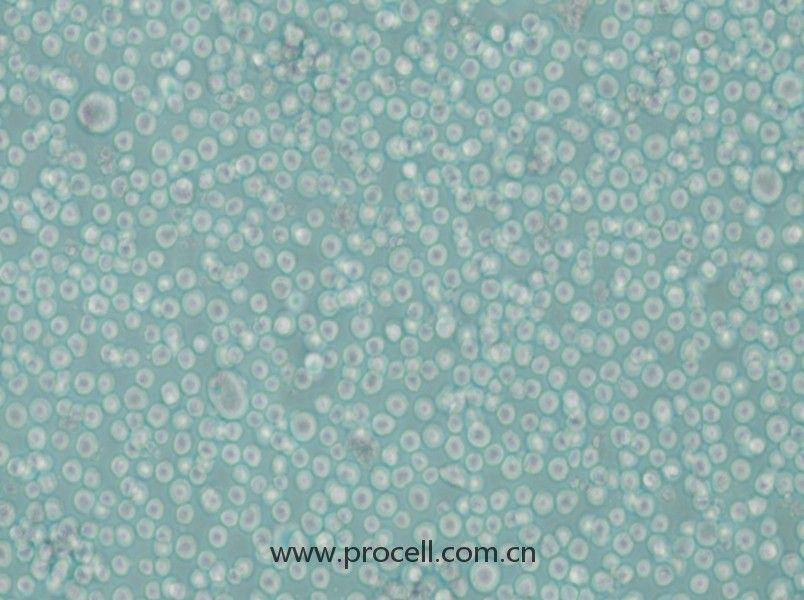
LAMA-84 (人多發(fā)性骨髓瘤細(xì)胞) (STR鑒定正確)

產(chǎn)品中心Cell Resources
聯(lián)系我們CONTACT US
400-999-210024小時服務(wù)熱線
產(chǎn)品概述
| 名稱 | LAMA-84 (人多發(fā)性骨髓瘤細(xì)胞) (STR鑒定正確) |
| 別稱 | Lama-84; LAMA84; Lama84 |
| 種屬 | 人 |
| 生長特性 | 懸浮細(xì)胞 |
| 細(xì)胞形態(tài) | 淋巴母細(xì)胞樣,圓形,單個細(xì)胞 |
| 凍存條件 | 凍存液:55% 基礎(chǔ)培養(yǎng)基+40%FBS+5%DMSO 溫度:液氮 |
| 培養(yǎng)方案A(默認(rèn)) |
培養(yǎng)條件:
氣相:空氣,95%;CO2,5%, 溫度:37℃
|
| 推薦傳代比例 | 1×10^5-1×10^6 cells/mL |
| 推薦換液頻率 | 2-3次/周 |
| 注意事項 | 該細(xì)胞用培養(yǎng)基培養(yǎng)會貼壁生長,需要用到未TC處理的培養(yǎng)瓶進(jìn)行培養(yǎng)。 |
| 背景描述 | LAMA-84是來源于急變期慢性髓性白血?。–ML)患者外周血的人類細(xì)胞系。該細(xì)胞系的特征是費(fèi)城染色體的存在,這導(dǎo)致了BCR-ABL融合基因,這是CML的一個標(biāo)志。已知BCR-ABL癌基因在增加酪氨酸激酶活性中的作用,酪氨酸激酶活性促進(jìn)各種信號通路,導(dǎo)致不受控制的細(xì)胞增殖和對凋亡的抵抗。因此,LAMA-84細(xì)胞是研究CML進(jìn)展的分子機(jī)制和在臨床前評估酪氨酸激酶抑制劑(TKIs)療效的一個非常有價值的模型。 在研究中,LAMA-84被廣泛用于了解慢性粒細(xì)胞白血病的生物學(xué),特別是在耐藥性和疾病演變的背景下。涉及該細(xì)胞系的研究有助于闡明細(xì)胞對不同代TKIs的反應(yīng),如伊馬替尼、達(dá)沙替尼和尼羅替尼。此外,LAMA-84有助于旨在克服TKI耐藥性的新治療策略的研究,包括針對受BCR-ABL融合蛋白協(xié)同影響的其他信號通路的聯(lián)合療法的測試。 |
| 年齡(性別) | 女性;29歲 |
| 組織來源 | 血液 |
| 細(xì)胞類型 | 腫瘤細(xì)胞 |
| 腫瘤類型 | 白血病細(xì)胞 |
| 生物安全等級 | BSL-1 |
| 倍增時間 | 48 hours |
| 抗原表達(dá)情況 | GPIIb/IIIa+, GPIIIa+ |
| 保藏機(jī)構(gòu) | DSMZ; ACC-168 |
STR鑒定
-
STR位點(diǎn)信息
Amelogenin X CSF1PO 11,12 D2S1338 17,19 D3S1358 14,17 D5S818 11,12 D7S820 11 D8S1179 10,15 D13S317 11,12 D16S539 11 D18S51 13 D19S433 13 D21S11 29,31 FGA 21,22 PentaD 10 PentaE 7 TH01 6,7 TPOX 10,11 vWA 14,17 D6S1043 10,20 D12S391 18,24 D2S441 11,11.3 -
STR鑒定圖
-
FAQs
Q:{{item.question}}
A:
產(chǎn)品資料
識別碼示意圖